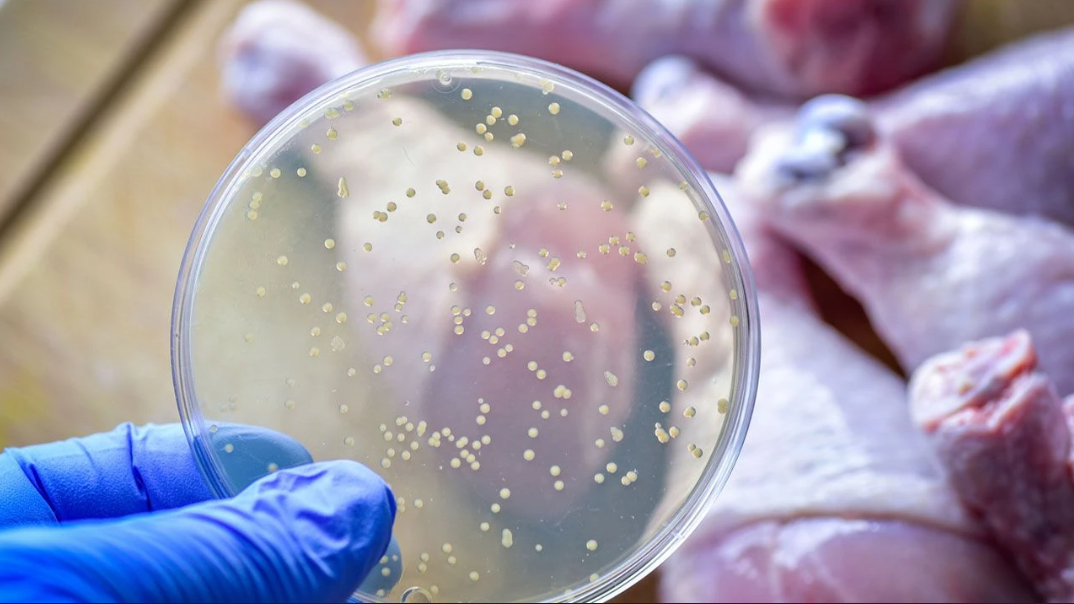
salmonella-1.png

İçme sularından bile bulaşabiliyor! Konya'daki uzman uyardı
Salmonella bakterisinin hijyenik olmayan, sağlıksız koşullarda üretilen/tüketilen gıdalardan veya zarar görmüş şebeke suyu borularından içme sularına bulaşabileceğini ifade eden Prof. Dr. Mustafa Karakaya, bu bakterinin ülkemizde hijyenik olmayan sağlıksız ortamlarda yaygın bir şekilde görülebileceğini belirtti.
Salmonella bakterisine hijyenik olmayan ortamlarda sıkça rastlanıyor. Özellikle hayvansal gıdalarda, sebze ve meyvelerde veya kanalizasyon suyunun karıştığı şebeke sularında sıkça bu bakterinin görüldüğünü aktaran Selçuk Üniversitesi Ziraat Fakültesi Gıda Mühendisliği Bölüm Başkanı Prof. Dr. Mustafa Karakaya, konu hakkında detaylı açıklamalarda bulundu.

Gıda işletmelerinde denetimlerin doğru bir şekilde yapılmasının yanı sıra evlerde de gerekli tedbirlerin alınması gerektiğini ifade eden Mustafa Karakaya, önemli uyarılarda bulundu.

‘HİJYENİK OLMAYAN ORTAMLARDA KARŞIMIZA ÇIKAR’
Bakteri hakkında detaylı bilgi veren Karakaya, “Salmonella bakterisi özellikle hijyenik olmayan ortamlarda ve sağlıksız koşullarda üretilen gıdalarda karşımıza çıkar. Genellikle hayvansal ürünlerde yaygın bir şekilde görülür. Bu bakteri insanların ve hayvanların bağırsaklarında yaşar, dışkı ile vücuttan atılır. Patojen hastalık yapma özelliğine sahiptir. Ateş, ishal, iştah kaybı, baş ağrısı, kramp, karın ağrısı, mide bulantısı, kusma gibi en belirgin emareler ile ortaya çıkar. Bu belirtiler sağlıksız ortamlarda üretilen kirli gıdalar vücuda alındıktan 12-36 saat sonra ortaya çıkar ve 2 ile 7 gün arasında devam eder.” şeklinde konuştu.
‘ÇOK SIK RASTLANIYOR’
Ülkemizde Salmonella bakterisine çok sık rastlanıldığını aktaran Karakaya, “Ülkemizde her gün çok sayıda gıda zehirlenmesi vakası yaşanıyor. Bu durumun ana sebebi sağlıksız ortamlarda gıdaların üretilmesinden kaynaklanıyor. Gıda zehirlenmesi olarak bahsedilen vakalar aslında çoğu zaman Salmonella enfeksiyonudur. Çok sık rastlanılır. Özellikle çiğ veya az pişmiş olarak tüketilen etlerde, pastörize edilmemiş sütler ve bu sütlerden üretilen ürünlerde salmonellaya sık sık rastlıyoruz. Bitkisel ürünlerde ve özellikle doğrudan toprakla temas halindeki yeşil yapraklı sebzelerde ve meyvelerde de rastlayabilmekteyiz. Sıça tükettiğimiz gıdalarımızdan biri olan yumurta çiğ olarak veya yetersiz pişirilmeden tüketilmemelidir. Her türlü mikrobu içerebilir. Etli çiğ köftede de karşımıza çıkabilir.” ifadelerine yer verdi.

‘YETERLİ SEVİYEDE TEMİZLENMELİ’
Hayvansal gıdaların, sebze ve meyvelerin yeterli düzeyde temizlenerek tüketilmesi gerektiğini vurgulayan Karakaya, “Örneğin yumurtanın üzerinde bulunabilecek tavuk dışkısı yumurtanın kırılması esnasında yemeğe bulaşırsa Salmonella riski oluşturur. Bu durum meyve ve sebzelerde de aynıdır. Çünkü yetiştirildiği yerde hayvanlar da gezebilmektedir. Burada bulunan ürünlere herhangi bir hayvanın dışkısı bulaşabiliyor. Dışkı bulaşan ürünü bir şekilde evimize getiriyoruz ve suya tutup sofralarımıza koyuyoruz. Yeterli seviyede yıkanıp/temizlenmediğinden, başta Salmonellalar olmak üzere her türlü mikroplar bulaşabiliyor.” diye aktardı.

‘DENETİM ÖNEMLİ’
Yaşanabilecek gıda zehirlenmelerine karşı gıda denetimlerin doğru bir şekilde yapılması gerektiğini vurgulayan Karakaya, “Yakın zamanda bir şehrimizde meydana gelen Salmonella vakası tavuk döner tüketiminden kaynaklandı. Döner hizmeti veren lokantalarda gün içerisinde satılmadan kalan dönerlerde Salmonella riski çok yüksek derecede artmaktadır. Nitekim bundan kaynaklanan gıda zehirlenmesi problemleriyle sık sık karşılaşılabilmektedir. Vatandaşlar gittikleri restoranların ne derece hijyenik olduğunu bilmeyebilirler. Bu nedenle her türlü gıdanın güvenli bir ortamda üretilip tüketiciye ulaştırılması gerekiyor. Bunun da çözümü denetimdir. Ülkemizde Tarım Bakanlığı tarafından çok sayıda denetimler yapılmakla birlikte yine de gıda zehirlenmesi vakalarıyla karşılaşılabilmektedir. Özellikle Gıda Denetçilerinin gıdaların tüm özellikleri hakkında yeterli bilgi birikimine sahip olması gerekiyor. Tarım Bakanlığı bünyesinde istihdam edilen denetçilerinde mutlaka gıda konusunda temel bilgi birikimine sahip Gıda mühendisleri vasıtasıyla gerçekleştirilmesi yaşanacak gıda zehirlenmesi vakalarının önlenmesi açısından önem arz etmektedir. Karakaya; gıdaların, gıda mühendisleri tarafından denetlemesinin sağlıklı gıda tüketimine çok önemli düzeyde katkısı olacağı.” şeklinde konuştu.

‘ŞEBEKE SULARINA DİKKAT EDİLMELİ’
Şebeke sularının geçtiği boruların hasar görmesi durumunda, kanalizasyon borularından bulaşabilecek mikropların içme sularında sorunlara yol açabileceğini ifade eden Karakaya, evlerde alınabilecek tedbirlerden şu şekilde bahsetti; “Evlerimizde de çeşitli tedbirler almalıyız. Özellikle sebze ve meyveleri karbonatlı veya sirkeli su içerisinde bekletmeliyiz. Ülkemizde çok fazla yaygın olmasa da en ekonomik yol “elektrolize iyonize su üreten cihazlar” tarafından üretilen suları kullanmaktır. Her şeyin temelinde yatan temizliktir. Bunun dışında sağlıklı su tüketimi de bu noktada çok önemlidir. Bölgemizde yakın zamanda lokal olarak sudan kaynaklanan bir salgın yaşandı ve yaşanmaya da devam ediyor. Şehir şebekelerinden evlere gönderilen suların mutlaka dezenfekte edilmesi gerekiyor. Eğer çeşme sularının geldiği yer altı borularında delinme, çatlama ve kırılmalar meydana geldiyse bölgedeki su taşıma sistemlerinin mutlaka yenilenmesi gerekiyor. Aksi takdirde kanalizasyon borularından sızan sular, şehir şebekesi suyuna karışarak musluklarımızdan Salmonella ve diğer birçok mikrop içeren sular vasıtasıyla salgınlar yaşanabilecektir.”
